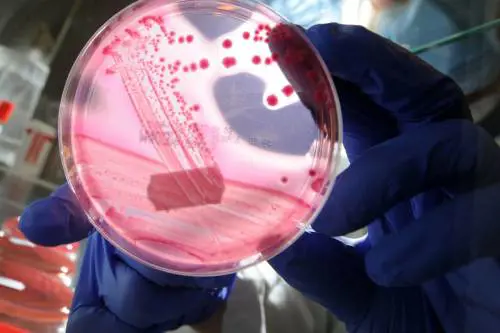
Resistenza agli antibiotici, nuova arma contro i batteri: ecco come eludono l'azione dei medicinali

Non bisogna abusare di antibiotici affidandosi al fai-da-te e soprattutto attendere che sia lo specialista a prescriverli: quali sono i numeri della resistenza batterica a questi farmaci

Non bisogna abusare di antibiotici affidandosi al fai-da-te e soprattutto attendere che sia lo specialista a prescriverli: quali sono i numeri della resistenza batterica a questi farmaci

Il farmaco ha raggiunto il 100% di efficacia su pazienti ritenuti incurabili: di cosa si tratta e come funziona. L'allarme: entro il 2040 si potrebbe salire a 40 milioni di morti a causa dei superbatteri

Questa strategia di difesa dei patogeni non era nota ai ricercatori, che ora potranno elaborare nuove strategie per contrastarli
La malattia, provocata dal batterio Neisseria gonorrhoeae, si trasmette a livello sessuale. Il Centro europeo per la prevenzione raccomanda il monitoraggio continuo

In Italia la prescrizione di antibiotici è eccessiva. Efficaci solo contro le malattie di origine batterica, a volte tendiamo a pensare che risolvano tutto e subito, ma questo non è vero. Qual è il loro meccanismo d'azione? Come prendere il trattamento antibiotico? Di fronte a un’infezione, come ottimizzare l’uso degli antibiotici senza favorire la resistenza dei batteri?

Cresce la resistenza dei batteri alla somministrazione degli antibiotici: ecco perché siamo arrivati a questo punto e quali sono le azioni da compiere

La Società Italiana di Neonatologia ha lanciato l'allarme sull'antibiotico resistenza, l'Italia è tra i Paesi con il maggior tasso di mortalità: ecco cosa significa e la ricerca giapponese contro questa problematica

L'Inghilterra adotta già da alcuni anni una terapia efficace per vincere la resistenza dei batteri: ecco qual è il ruolo dei vermi e cosa ne pensano i medici

In Veneto c’è un fungo killer che resiste agli antibiotici e ha già provocato la morte di un uomo. Ha una mortalità tra il 20 e il 70% e può rimanere a lungo sulle superfici

A lanciare l'allarme Giorgio Palù, professore emerito di microbiologia e virologia all'università di Padova
